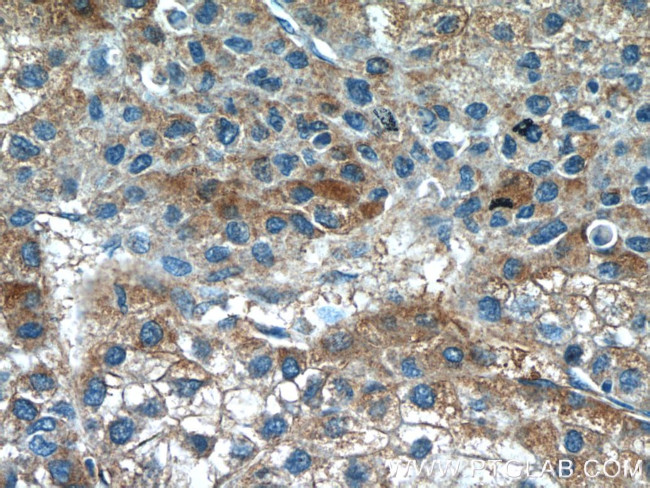
GTSE1 Antibody in Immunohistochemistry (Paraffin) (IHC (P))

Search
Proteintech
GTSE1 Polyclonal Antibody
{{$productOrderCtrl.translations['antibody.pdp.commerceCard.promotion.promotions']}}
{{$productOrderCtrl.translations['antibody.pdp.commerceCard.promotion.viewpromo']}}
{{$productOrderCtrl.translations['antibody.pdp.commerceCard.promotion.promocode']}}: {{promo.promoCode}} {{promo.promoTitle}} {{promo.promoDescription}}. {{$productOrderCtrl.translations['antibody.pdp.commerceCard.promotion.learnmore']}}
产品信息
21319-1-AP
种属反应
已发表种属
宿主/亚型
分类
类型
抗原
偶联物
形式
浓度
规格
纯化类型
保存液
内含物
保存条件
运输条件
产品详细信息
Immunogen sequence: CAWSESSQL NKTRSIRRRD SCLNSKTKVM PTPTNQFKIP KFSIGDSPDS STPKLSRAQR PQSCTSVGRV TVHSTPVRRS SGPAPQSLLS ARRVSALPTP ASRRCSGLPP MTPKTMPRAV GSPLCVPARR RSSEPRKNSA MRTEPTRESN RKTDSRLVDV SPDRGSPPSR VPQALNFSPE ESDSTFSKST ATEVAREEAK PGGDAAPSEA LLVDIKLEPL AVTPDAASQP LIDLPLIDFC DTPEAHVAVG SESRPLIDLM TNTPDMNKNV AKPSPVVGQL IDLSSPLIQL SPEADKENVD SPLLKF (416-720 aa encoded by BC006325)
靶标信息
The protein encoded by this gene is only expressed in the S and G2 phases of the cell cycle, where it colocalizes with cytoplasmic tubulin and microtubules. In response to DNA damage, the encoded protein accumulates in the nucleus and binds the tumor suppressor protein p53, shuttling it out of the nucleus and repressing its ability to induce apoptosis.
仅用于科研。不用于诊断过程。未经明确授权不得转售。
生物信息学
蛋白别名: G two S phase expressed protein 1; G-2 and S-phase expressed 1; G2 and S phase-expressed protein 1; GTSE-1; GTSE1; Lnc_bc060912; Protein B99; Protein B99 homolog; similar to Mus musculus B99 protein; unnamed protein product
基因别名: B99; Gtse-1; GTSE1; RGD1563164
UniProt ID: (Human) Q9NYZ3, (Mouse) Q8R080
Entrez Gene ID: (Human) 51512, (Rat) 300126, (Mouse) 29870